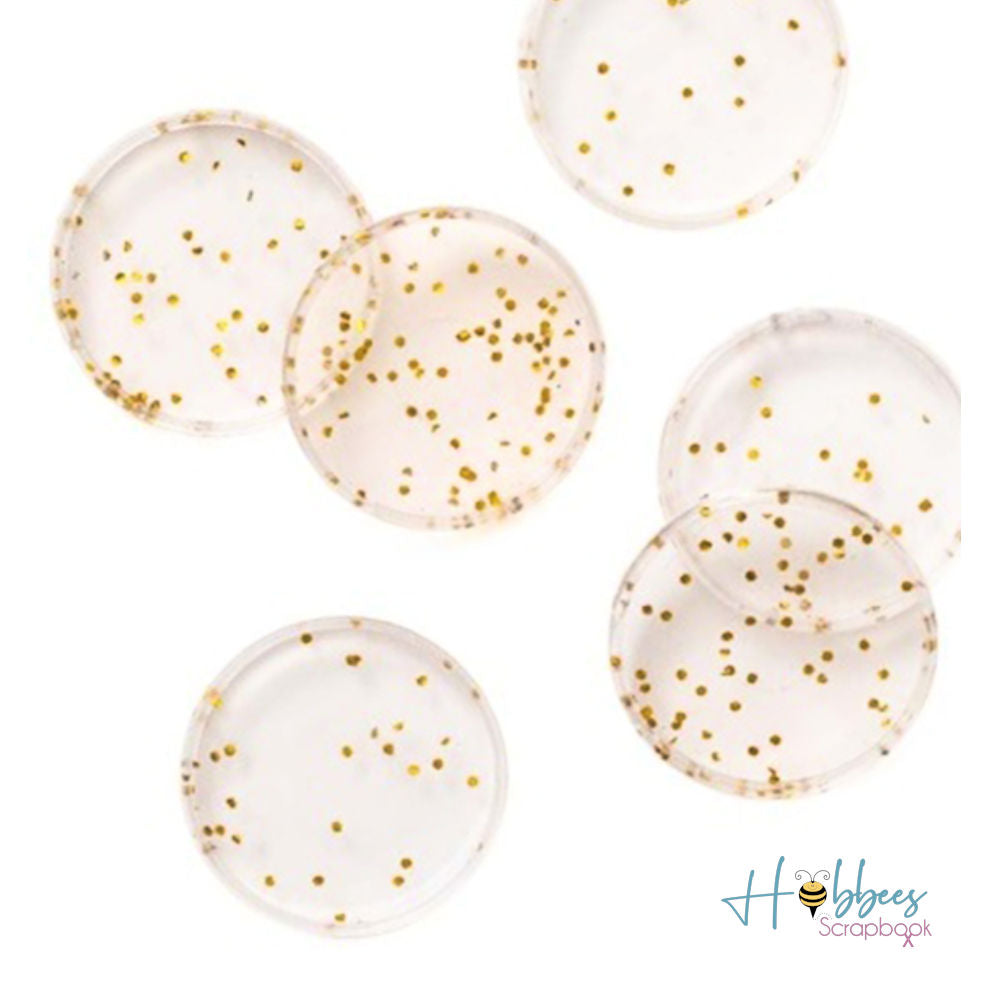
Medium Discs Gold Glitter / Discos para Agendas Glitter Dorado DESCONTINUADO Maggie Holmes

Compartir este producto
1
/
de
3
Medium Discs Gold Glitter / Discos para Agendas Glitter Dorado
373034
- Precio regular
-
$ 159.00 - Precio regular
-
- Precio de venta
-
$ 159.00
No se pudo cargar la disponibilidad de recogida
Listo! Recibirás un correo en cuanto lo tengamos disponible nuevamente.
Hubo un error, favor de intentar de nuevo.
Anillos o discos medianos para sustituir los de tu planificador Day to Day Planner de Maggie Holmes, hacer una nueva agenda o crear un álbum desde cero.
Muy útiles si no quieres cargar con toda la agenda completa, divide tu planner e incluye los meses que necesitas en estos bonitos anillos o discos.
Fabricados en plástico.
Compatibles con Happy Planner.
El paquete contiene:
- 9 discos de plástico para agendas que miden 3.5 cm de diámetro
Compra ahora y paga a meses sin tarjeta de crédito
1
2
3
Crédito sujeto a aprobación.
¿Tienes dudas? Consulta nuestra Ayuda.
Información de envio
Normalmente se envía al día hábil siguiente o antes.
METODOS DE PAGO

Medium Discs Gold Glitter / Discos para Agendas Glitter Dorado
- Precio regular
-
$ 159.00 - Precio regular
-
- Precio de venta
-
$ 159.00